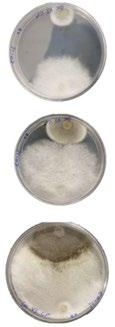
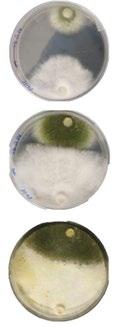
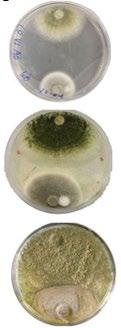

REFRAME: STEWARDSHIP
DESIGN ACTIVELY IN RESPONSE TO ENVIRONMENTAL CHALLENGES
PROJECT1: MYCELIUM SOIL REMEDIATION FACTORY
PROJECT2: AERODYNAMIC DESIGN APPARATUS
PROJECT3: GEOMORPHOLOGY RESEARCH CENTRE (CLIFF PART)
PROJECT4: GEOMORPHOLOGY RESEARCH CENTRE (DUNE PART)
PROJECT5: WEDGE (WORK SELECTED)
PROJECT6: CHOGA (CLEANTECH START UP)
PROJECT7: OTHER WORKS
SHUHENG WANG
A Portfolio By Shuheng Wang
Digital Portfolio
MYCELIUM SOIL REMEDIATION FACTORY
Project Duration: 2022-2023/ Year 2 Building Project
Project Tutor: Zach Fluker, Jhono Bennet
Key Words: Mycelium, Mycoremediation, Self-Build
The Mycelium Factory Project is an architectural and ecological intervention that explores the potential of mycelium as a transformative biological building material. This project operates with a dual objective: social empowerment and environmental remediation. First, it aims to democratize architecture by equipping local communities with accessible, low-tech "self-build" techniques, transforming residents from passive occupants into active builders of their environment. Second, the project serves as an active agent in ecological healing; by cultivating specific fungal strains, the factory utilizes mycoremediation to detoxify and regenerate heavily contaminated land. Ultimately, the Mycelium Factory is not just a site of production, but a living infrastructure that heals the earth while empowering the people who inhabit it.
Material Exploration: To investigate and test various manufacturing methods of mycelium composites focusing on low-tech , locally adaptable cultivation processes.
Application Strategy: To identify specific, viable architectural applications for mycelium that can be safely and efficiently executed by nonprofessionals within a self-build context.
Theoretical Innovation: To synthesize these material and practical findings into a comprehensive " Mycelium-Assisted Self-Build Framework," proposing a new paradigm for decentralized, sustainable, and community-empowered architecture.
AN OVER VIEW OF MYCELIUM (MUSHROOMS)








USE AND LIFECYCLE OF MYCELIUM Oyster mushroom as Exapmle
PROCESS OF UTILIZING



















MYCELIUM PRODUCED
MYCELIUMMUSHROOM
SMALL MUSHROOM
MUSHROOM
PROJECT FRAMEWORK
A.SITE ANALYSING

B. PROBLEM VERIFYING
The experiment observed the physiological development of plants cultivated in the site's polluted soil against a control group grown in healthy, uncontaminated soil. The results were visually and biologically stark: plants in the site soil exhibited significant morphological abnormalities, stunted growth, and clear signs of phytotoxicity. This physical evidence highlights the severe degradation of the site's ecosystem and underscores the urgent necessity for the mycoremediation strategies proposed by the Mycelium Factory.













RESEARCH: SOIL REMEDIATION THROUGH MYCELIUM

EXPERIMENT PROCESS: CHOOSING SUITABLE FUNGI

DESIGN SOLUTION-“MYCELIUM EMPOWERED SELF-BUILD”
EXPERIMENT SUBJECT: PARK IN ZAMBIA





MYCOREMEDIATION: RESULT






PROJECT INTURN EMPOWERS THE COMMUNITY WITH SKILLS

CONTRIBUTE TO MAKING MYCELIUM ARCHITECTURE COMPONENTS


As the site of this building, adds a number of elements to the project that we can explore. Sand, as the main material of the geological composition of the site, interacts with the wind THE MYCELIUM FACTORY REMEDIATES THE LOCAL SOIL & CULTIVATE SPORES


A. Cladosporium Cladosporioides
A. Cladosporium Cladosporioides
B. Geotrichum Candidum
B. Geotrichum Candidum
C. Aspergillus transmontanensis
Aspergillus transmontanensis
GF : RECEPTION,EXHIBITION
MYCELIUM ADVANTAGE: AESTHETIC-BIOPHILIC DESIGN

Unlike the coldness of concrete or the artificiality of plastic, mycelium composites typically possess a micro-texture reminiscent of velvet, cork, or dry earth. This warm, organic touch directly awakens our innate, genetic connection to soil and forests. Therefore used as the primary tiling material.
FLOOR 1
MYCELIUM PANEL (CEILING)
MYCELIUM PANEL (INTERIOR)
MYCELIUM BRICK WALL (INNER WALL) MYCELIUM BRICK WALL
FRAME
B2: SOIL REMEDIATION FACTORY
DISADVANTAGE: WEIGHT BEARING

Pure mycelium presents strict mechanical boundaries in architectural applications: functioning similarly to polymeric foams, it exhibits moderate compressive strength but extremely low tensile and shear strength. Therefore it needs timer or metal strcture to bear the load for it.
GROUND FLOOR
MYCELIUM PANEL (EXTERIOR)
MYCELIUM PANEL (INTERIOR)

B1:LAB,WORKSHOP
ADVANTAGE: SOUND INSULATION

Due to the inherent micro-porosity of the fungal network, mycelium panels boast a Noise Reduction Coefficient (NRC) comparable to commercial acoustic foams. Therefore the mycelium panel is used between floor panels and used as inner wall material

MYCELIUM MATERIAL INITIAL TEST
a
of
UNDERGROUND FLOOR 2
MYCELIUM PANEL (EXTERIOR)
MYCELIUM REINFORCED RAMMED EARTH








Mycelium presents a revolutionary shift in sustainable architecture, characterized by its zerocarbon, fully circular lifecycle where the carbon-negative growth process ultimately yields a 100% compostable material. Despite these exceptional ecological and physical strengths, pure mycelium composites possess critical limitations that prevent them from being used in isolation. The material is foam-like and extremely brittle, resulting in exceptionally low tensile and shear strength that disqualifies it as a primary load-bearing element for multi-story structures.
To safely and durably integrate mycelium into grassroots "self-build" scenarios, these limitations must be mitigated through hybrid structural assemblies. First, addressing load-bearing limits requires a "bone and flesh" structural synergy; a traditional light timber framework handles gravity loads, while prefabricated "Timber-Mycelium Cassettes" serve as the lightweight, insulating infill. Second,natural plant fiber meshes can be layered inside the molds during cultivation to act as a"biological rebar," providing crucial tensile stress resistance against sudden impact or bending.
Rubjerg Knude, as the site of this building, adds
number
elements to the project that we can explore. Sand, as the main material of the
BUILDING WITH MYCELIUM
STRUCTURE DIAGRAM MYCELIUM PANEL MODEL

To ensure the construction process is highly accessible to community members, the assembly utilizes a "Modular Friction Fit" logic.The timber framework is designed with standardized grooves or a grid system.
ROOF EXPLOSION DIAGRAM

The building's exterior roof is clad in overlapping, prefabricated mycelium panels, creating an organic architectural
While traditional rammed earth is inherently weak in tension and prone to shrinkage cracking, mycelium hyphae act as a microscopic, 3D biological mesh. This living matrix deeply binds the soil particles together, significantly increasing the material's tensile strength and structural ductility.
RAMMED EARTH STRUCTURE
RAMMED EARTH B. MYCELIUM REINFORCED RAMMED EARTH



C. MYCELIUM BRICK KILN/ WALL
I developed an adaptable mold system for mycelium bricks, featuring manual hole-positioning that facilitates integration with steel frameworks, which simplifies the fabrication of complex geometries while maintaining structural integrity.
BRICK STRUCTURE EXPLORATION


ARCHITECTURE SECTIONAL RENDER


The Mycelium Panel Ceiling
Mycelium Reinforced Rammed Earth
Mycelium Brick Kiln
MYCELIUM BRICK
MYCELIUM
A. MYCELIUM PANEL ROOFING
MYCELIUM BRICK MOULD
COMMUNITY
To dismantle the knowledge barrier between advanced bio-design and the general public, I designed a website for this project.
This digital platform serves as the central operational hub connecting the Mycelium Factory with the local community.
Through this portal, residents can seamlessly transition from learning to action: they can claim a customizable brick mold, register for weekend assembly workshops, or track the real-time ecological recovery of the neighborhood's polluted sites via a live interactive map.
By leveraging digital open-source sharing, this website transforms a topdown architectural experiment into a grassroots, bottom-up community building movement.






Make and sell Mycelium Building Components at Home in 9 Steps!
Mycelium bricks are typically produced through a nine - step biofabrication process: selecting an appropriate fungal strain and lignocellulosic substrate; preparing and hydrating the substrate; sterilizing or pasteurizing it; inoculating it with mycelium spawn; packing the mixture into a brick mold; incubating it under controlled conditions; demolding it after sufficient colonization; allowing further surface growth if necessary; and finally drying the brick to deactivate the fungus and stabilize the material.
1. Select the substrate- Cardboard
Choose a suitable fungal species and a lignocellulosic substrate such as sawdust, straw, hemp hurds, or other agricultural fibers, since both strongly influence the final material properties.
2. Prepare the substrate.
Shred or sieve the substrate to achieve a relatively consistent particle size, then remove any unwanted contaminants so the material is easier for the mycelium to colonize.
3. Adjust the moisture content.
Add water until the substrate is adequately hydrated, as fungal growth depends on sufficient moisture.











FINAL ARCHITECTURE MODEL





SITE RESEARCH



MYCELIUM LAB
MYCELIUM LAB (EXTERIOR)
AERODYNAMIC DESIGN APPARATUS
Project Duration: 2023-2024 / Y3 Research Project
Project Tutor: Ben Spong, Stefan Legan
Key Words: Aero Dynamic Design, Passive Design
PROJECT STATEMENT
Through
PROJECT AIM
Morphological Interplay and Aerodynamic Dynamics: Investigate how diverse geometric morphologies and surface textures
Wind Manipulate Devices: Design and prototype adaptive devices capable of manipulating wind behavior. Tools for Aerodynamic: DesignDevelop an intuition-led aerodynamic design toolkit that demystifies complex fluid mechanics, enabling designers to visualize and utilize the invisible medium of wind with precision and ease.
HOW CAN DESIGNERS LEARN TO HARNESS SITE-SPECIFIC WIND CONDITIONS IN ARCHITECTURAL DESIGN? WIND MANIPULATE PROTOTYPE

AERODYNAMIC ANALYSIS


AERODYNAMIC RESEARCH
In































































APPARATUS DESIGN & MANUFACTURE








WIND STUDY APPARATUS

GEOMORPHOLOGY RESEARCH CENTRE (CLIFF PART)
Project Duration: 2023-2024 / Y3 Building Project
Tutor:
Key Words: Aero Dynamic Design, Passive Design
HOW TO UTILIZE NATURAL EROSION PHENOMENON TO GENERATE NEGATIVE SPACES WITHIN A CLIFFSIDE?
PROJECT STATEMENT
This project investigates the erosive phenomena at the Rubjerg Knude cliffs as a generative force for architectural intervention. By strategically manipulating on-site wind dynamics, the project attempts to utilize natural erosion as a 'biological carving tool' to create functional negative spaces within the building mass. This approach challenges the conventional boundaries of Passive Design, proposing a shift from static environmental defense to a dynamic, time-based co-evolution between the built form and ecological decay.
PROJECT AIM
Morphological & Temporal Analysis:
To investigate the natural erosion phenomena at Rubjerg Knude, deciphering its intricate textures and temporal cycles as a basis for generative design.
Subtractive Spatial Creation via Minimal Intervention
To explore strategies for creating functional architectural spaces by leveraging erosion through minimal human interventions, shifting from additive construction to a subtractive "carving" process.
Integrated Programming for Research and Tourism
To develop a spatial framework that harmonizes scientific monitoring with immersive visitor experiences within the evolving cliffside environment.
Project
Ben Spong, Stefan Legan
02 SITE RESEARCH
Rubjerg Knude, as the site of this building, adds a number of elements to the project that we can explore. Sand, as the main material of the geological composition of the site, interacts with the wind and creates wonderful natural phenomena. Therefore, the building tries to manipulate two natural phenomena related to sand, namely Sand Accumulation and Erosion, through wind.More specifically, the building creates a sense of wonder through accelerating the speed of landscape forming






The area receives a consistent amount of rainfall throughout the year. There are no distinct dry seasons, although precipitation can be slightly higher during the autumn and winter months. Daylight varies significantly throughout the year due to Denmark's northern latitude. Long days in the summer with up to 17-18 hours of daylight contrast sharply with the short days of winter, which can have fewer than 7 hours of daylight.





Figure.01__Winter in Rubjerg Knude
Figure.01__Winter in Rubjerg Knude
Figure.01__Winter in Rubjerg Knude
Figure.01__Winter in Rubjerg Knude
Figure.02__Summer in Rubjerg Knude
B C Rubjerg Knude Cliff
Rubjerg Knude Sand Dunes Centre
Rubjerg Knude Entry
THE VENTURI EFFECT
The





To validate the hypothesized aerodynamic strategies, conducted a physical simulation using a controlled sandblasting apparatus on plaster-cast cliff prototypes. The plaster serves as a sacrificial medium, its uniform density allowing for precise measurement of material loss. The experiment tested various geometric interventions—including convergent 'Venturi' funnels and textured turbulence-inducers. Results confirmed that strategic geometries can effectively 'focus' the abrasive energy of airborne particles, accelerating localized erosion












ERODED SPACE SIMULATION RENDER




05 BUILDING TOOL DESIGN















Rubjerg Knude, as the site of this building, adds a number of elements to the project that we can explore. Sand, as the main material of the geological composition of the site, interacts with the wind and creates wonderful natural phenomena. Therefore, the building tries to manipulate two natural phenomena related to sand
CLIFF PLATFORM
WIND FARM
GUEST ROOM MORNING
GUEST ROOM NIGHT
GEOMORPHOLOGY RESEARCH CENTRE (DUNE PART)
Project Duration: 2023-2024 / Y3 Building Project
Project Tutor: Ben Spong, Stefan Legan
Key Words: Extreme Architecture, Passive Design
HOW TO DESIGN ARCHITECTURE UNDER EXTREME DESERT TERRAIN AND MANIPULATE DUNE MIGRATION?
PROJECT STATEMENT
This project proposes an architectural intervention within the perpetually shifting landscape of Rubjerg Knude, a site renowned for its volatile dune morphology. Constructing a permanent structure in such an environment demands a radical departure from traditional stability; instead, it requires a design that embraces environmental flux.
The architecture boldly attempts to manipulate dune formation through its own aerodynamic geometry. By strategically altering local wind patterns, the built form acts as a physical catalyst for sand deposition and erosion. This proactive engagement transforms the building into a live scientific instrument, providing a controlled environment for researchers to decode the complex laws governing dune migration and sediment dynamics. Here, permanence is achieved not through rigidity, but through the building’s ability to co-evolve with the desert's restless rhythm.
PROJECT AIM
Geomorphological Research:
To decode the fundamental principles of sand dune morphogenesis and explore the potential of architectural design to actively influence these geological formations. By treating the built form as a fluid-dynamic catalyst, the project seeks to manipulate sand deposition patterns through strategic geometric interventions.
Building in extreme desert terrain:
The research focuses on the aerodynamic optimization of architectural envelopes. This aims to mitigate structural challenges inherent in extreme desert conditions, such as mechanical weathering and excessive sand accumulation. Through precise morphological control, the architecture is designed to harmonize with the relentless kinetic energy of the site, ensuring long-term resilience within a perpetually shifting landscape.

SITE RESEARCH
Rubjerg Knude is defined by its extraordinary geological volatility. Driven by the relentless North Sea winds, the site's massive sand dunes are in a state of perpetual migration. In a span of just a few years, the dune crest can shift inland by tens of meters, redrawing the site’s topography and burying any static landmarks in its path. This rapid coastal retreat and dune migration present a radical challenge to architectural permanence. For this project, the site is not viewed as a fixed plot of land, but as a fluid, time-based process.
DUNE MIGRATION
Dune migration is a dynamic geomorphological process driven by aeolian transport, primarily through saltation. At Rubjerg Knude, the steep coastal cliffs amplify wind speeds, creating a high-energy environment where dunes act as fluid masses, constantly eroding on the windward side and depositing on the leeward slip face.


A.Saltation-70%
When wind velocity reaches a critical threshold, sand grains are lifted into the air and then pulled back down by gravity.
B.Surface Creep-20%
Larger, heavier sand particles that cannot be lifted into the air move via surface creep. When these grains are struck by saltating particles, they roll or slide slowly along the ground, much like the movement of billiard balls.
C.Suspension-10%
Extremely fine dust particles are lifted high into the atmosphere by the wind. These particles can remain airborne over vast distances before eventually settling.


BARCHAN DUNES
PARABOLIC
BARCHAN
RESEARCH













DESERT ENDURING DESIGN
To ensure the longevity of the structure within the volatile Rubjerg Knude landscape, the project integrates a series of strategies designed to minimize the impact of sand migration and mechanical weathering.
Key interventions include a system of elevated walkways that lift the circulation above the shifting terrain. This configuration creates an aerodynamic 'bypass,' allowing sand-laden winds to flow freely beneath the structure, thereby preventing sand accumulation and burial. Furthermore, strategic areas prone to high-velocity winds are reinforced with industrial wire mesh. This mesh acts as an energy-dissipating shield, breaking the kinetic force of saltating sand particles and protecting the primary architectural skin from the abrasive 'sandblasting' effect. Together, these measures shift the architectural paradigm from rigid resistance to adaptive endurance.



ROOF VIEW
05
ENGAGE WITH SAND
Rubjerg Knude, as the site of this building, adds a number of elements to the project that we can explore. Sand, as the main material of the geological composition of the site, interacts with the wind and creates wonderful natural phenomena. Therefore, the building tries to manipulate two natural phenomena related to sand, namely Sand Accumulation and Erosion, through wind.More specifically, the building creates a sense of wonder through accelerating the speed of landscape forming.
SMALL WIND LAB ON ROOF

Users:
Visitor+Reasercher
Time: Januarary

Time: March
Users:
Visitor+Reasercher


Time: APRIL

DUNE FORMING OBSERVATION
Within a single annual cycle, the designated Test Field functions as an accelerated geomorphological laboratory. Through its strategic aerodynamic layout, the field actively catalyzes both the formation and depletion of sand dunes, compressing decades of natural evolution into observable seasonal rhythms. This dynamic transformation is choreographed for dual engagement: while researchers utilize the rooftop mobile lab to gather high-fidelity data on sediment dynamics from a strategic vantage point, visitors are invited to witness the 'restless landscape' from multiple perspectives.
FINAL PLAN (GF)
Ground Floor
The ground floor is conceptualized as the primary public interface, acting as a resilient anchor within the shifting landscape. It serves as the main pavilion for visitor reception and environmental education, grounding the architectural experience before it extends into the cliffside.
A strategic subterranean passage directly links this terrestrial hub to the negative spaces carved within the Rubjerg Knude cliffs. This tunnel functions as a sensory transition, shielding visitors from the harsh coastal gales while guiding them toward the heart of the erosive voids. By occupying these 'hollowed-out' geological chambers, visitors can experience firsthand the subtractive beauty of the landscape—where the boundary between the constructed ground floor and the wind-sculpted cliffside becomes blurred.
PROFESSIONAL EXPERIENCE: WEDGE






DESIGN WORKS



EPOCH II
EPOCH II
DELOS SERIES
DESIGN

CORPORATE FOUNDED: 2025
CO-FOUNDER: PEIYAN ZOU
CORPORATE VISION
At CHOGA, we envision a future in which sustainable materials are not merely substitutes, but drivers of new aesthetic languages, emotional connection, and market transformation. Through material innovation, experimental design, and responsible commercial practice, we seek to create objects that deepen the relationship between people, design, and the environment, while shaping stronger demand for a more sustainable way of living.
MATERIAL DEVELOPMENT
CHOGA’s material development focuses not only on using BrightOrb as a more sustainable alternative to traditional ceramics, but on developing it into a more mature material system across performance, aesthetics, and sustainability. As our research progressed, it became clear that this could not be achieved through material substitution alone: if post-processing continued to rely on conventional heavy-metal-based glazes, much of BrightOrb’s environmental potential would be undermined. Our glazing research therefore became essential. It aims not only to reduce the environmental cost of post-processing, but also to develop a surface treatment better suited to BrightOrb’s own material properties, while strengthening its visual identity and product viability.
Material: FINE-Bz (BrightOrb) Carbon Foot Print Comparison








CONVENTIONAL CERAMIC PRODUCTION
Traditional ceramic manufacturing carries environmental burdens across multiple stages, particularly through particulate emissions during material preparation, heavy-metal-related risks in glazing, and the high energy consumption and flue-gas emissions associated with high-temperature firing.
A.RAW MATERIAL EXTRACTION

Conventional ceramics depend on virgin mineral extraction, a process that can generate dust pollution, disturb

Traditional forming often relies on labourintensive, mould-based processes that generate material waste and limit efficiency, especially when producing customised or complex forms.
BRIGHTORB PRODUCTION
A.MATERIAL: BRIGHTORB


Unlike conventional hand-forming and mouldbased shaping, SLS 3D printing enables precise, mould-free fabrication with lower material waste and greater design efficiency. It also supports on-demand production, reducing overproduction and unnecessary processing.

Conventional glazing commonly depends on chemical formulations that may contain heavy metals, creating environmental and health risks during material handling, application, and disposal.


and
CHOGA R&D

Traditional glazing often depends on heavymetal-based formulations. CHOGA’s current research focuses on developing a heavy-metalfree glazing process, aiming to reduce toxic material use while creating a surface treatment better suited to BrightOrb’s own material properties.

with the

MATERIAL R&D
GEOMETRY TEST AND GLAZING TEST





MATERIAL TEST FORMING PRECISION TEST
Rubjerg Knude, as the site of this building, adds a number of elements to the project that we can explore. Sand, as the main material of the geological composition of the site, interacts witrelated to sand, namely

2026SS ACCESSORIES COLLECTION (Concept Design)
-SCULPTURE- -NATUREFRACTURE-


-SCULPTURE-

-INCENSE HOLDER-













OTHER WORKS

